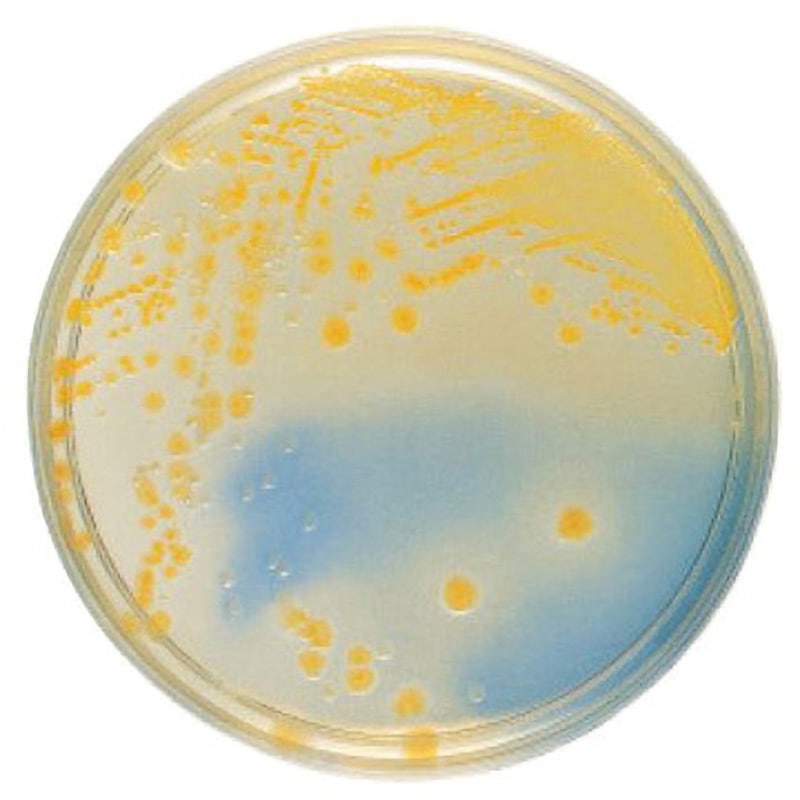

マイストア
変更
お店で受け取る
(送料無料)
配送する
納期目安:
2025.09.29 0:0頃のお届け予定です。
決済方法が、クレジット、代金引換の場合に限ります。その他の決済方法の場合はこちらをご確認ください。
※土・日・祝日の注文の場合や在庫状況によって、商品のお届けにお時間をいただく場合がございます。
颯ページ 251953 BD BBL TM CLED寒天培地 ベクトン・ディッキンソン 冷蔵の詳細情報
251953 BD BBL TM CLED寒天培地 ベクトン・ディッキンソン 冷蔵。ONLINE限定】COOLMAXベスト12G〈ハイゲージ〉薄手(シャーベット。瞬足 JB-162 ラベンダー|ベビーシューズ|脳トレ機能|3E。颯ページですꕤ︎︎·͜·BTS アクリルキーリング OT7 var. 1300円海外製品になりますので初期難等ご理解頂ける方のみご購入をお願いします。。Webike | K's-STYLE ケイズスタイル 低反発ローシート Ninja ZX。神経質な方は購入をお控え下さい。
ベストセラーランキングです
近くの売り場の商品
カスタマーレビュー
オススメ度 4.5点
現在、4475件のレビューが投稿されています。

























